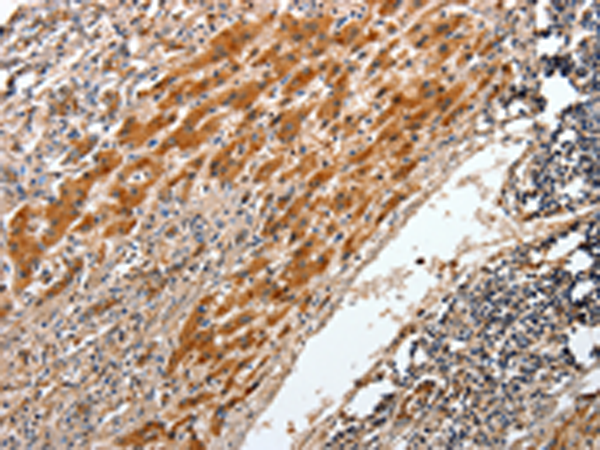
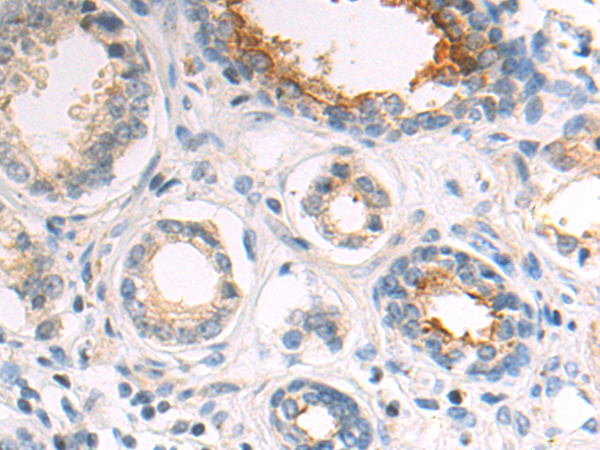

-
分类: 科研抗体货号: P10715别名:应用: WB,IHC反应种属: Human
-
分类: 科研抗体货号: P10717别名: ATG6; VPS30; beclin1应用: WB,IHC反应种属: Human, Mouse, Rat
-
分类: 科研抗体货号: P10738别名: TARC; ABCD-2; SCYA17; A-152E5.3应用: WB,IHC反应种属: Human, Mouse
-
分类: 科研抗体货号: P10714别名: NS5ATP1应用: IHC反应种属: Human, Mouse, Rat
-
分类: 科研抗体货号: P10736别名: MCP-4, NCC1, CKb10, NCC-1, SCYL1, SCYA13应用: IHC反应种属: Human
-
分类: 科研抗体货号: P10713别名: B7X; B7H4; B7S1; B7-H4; B7h.5; VCTN1; PRO1291; RP11-229A19.4应用: IHC反应种属: Human, Mouse, Rat
-
分类: 科研抗体货号: P10734别名: CBX; M31; MOD1; p25beta; HP1-BETA; HP1Hsbeta; HP1Hs-beta应用: IHC反应种属: Human, Mouse
-
分类: 科研抗体货号: P10711别名: B2R; BK2; BK-2; BKR2; BRB2应用: WB,IHC反应种属: Human, Mouse, Rat
-
分类: 科研抗体货号: P10731别名: DP3, PDGB, PKGB, CTNNG, DPIII, ARVD12应用: WB,IHC反应种属: Human, Mouse, Rat
-
分类: 科研抗体货号: P10710别名: PDCD12应用: WB,IHC反应种属: Human, Mouse

鄂公网安备42018502007531号
鄂公网安备42018502007531号

